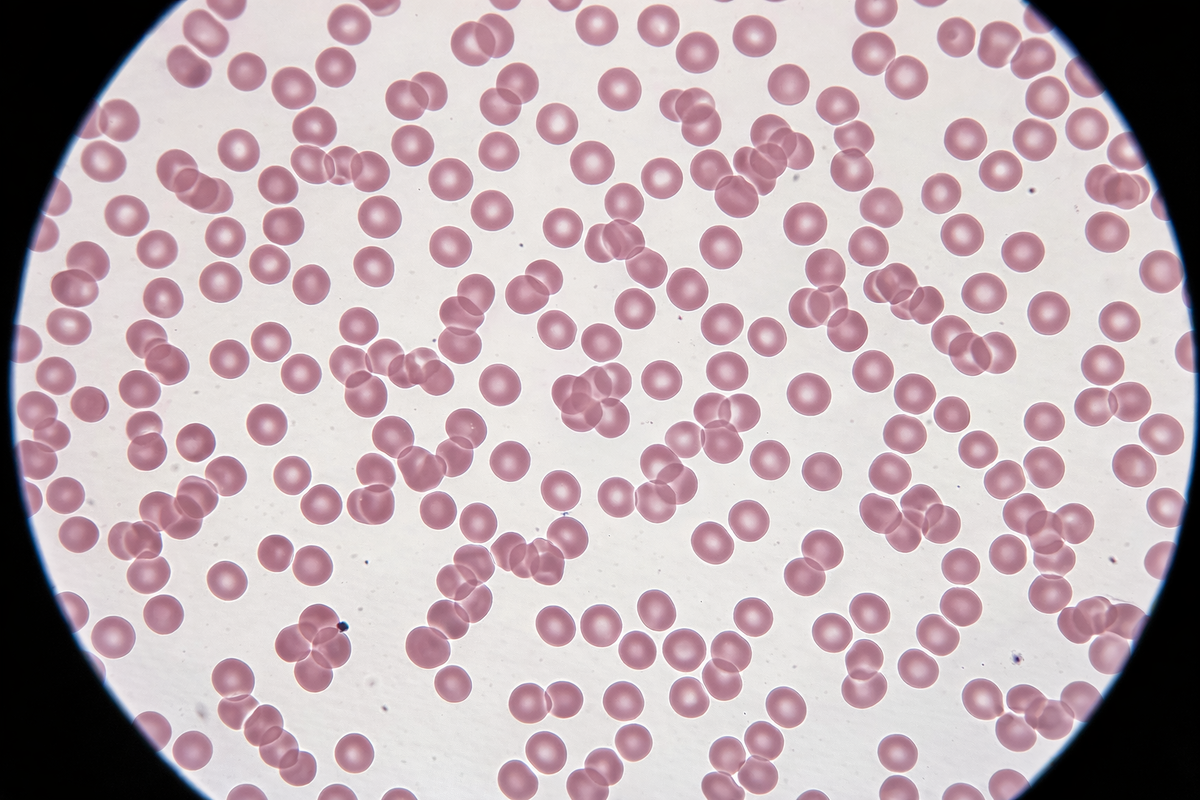
Niedriger Hb-Wert und Hämatokrit: häufige Ursachen wie Eisenmangel, Blutverlust und Vitaminmangel

Hb-Wert zu niedrig? Hämoglobin, Hämatokrit, Normalwerte & Ursachen einfach erklärt
Der Hb-Wert, das Hämoglobin und der Hämatokrit gehören zu den wichtigsten roten Blutwerten. Sie zeigen, wie gut der Körper Sauerstoff transportieren kann – und ob Hinweise auf Blutarmut, Eisenmangel, Blutverlust oder einen Vitamin-B12-Mangel bestehen.
Diese Seite ist Teil unseres Blutbild-Clusters: BB Blutwert / Blutbild, MCV, MCH, MCHC, Erythrozyten, Eisenmangel und Vitamin B12.

Schnellüberblick: Hämatokrit, Hb-Wert und Hämoglobin
Hb-Wert und Hämatokrit: typische Normalwerte
Die genauen Referenzbereiche können je nach Labor leicht abweichen. Trotzdem helfen typische Orientierungswerte, den Befund besser einzuordnen. Wichtig ist immer: Laborwerte werden nicht allein nach Tabelle beurteilt, sondern zusammen mit Beschwerden, Alter, Vorerkrankungen und Verlauf.
| Wert | Frauen | Männer | Bedeutung |
|---|---|---|---|
| Hb-Wert / Hämoglobin | ca. 12–16 g/dl | ca. 13,5–17,5 g/dl | Roter Blutfarbstoff, wichtig für den Sauerstofftransport |
| Hämatokrit | ca. 36–46 % | ca. 40–52 % | Anteil der roten Blutkörperchen am Blutvolumen |
| Erythrozyten | laborabhängig | laborabhängig | Rote Blutkörperchen, in denen Hämoglobin transportiert wird |
Ergänzend wichtig: Erythrozyten, MCV, MCH und MCHC, Ferritin/Eisenstatus, Vitamin B12 und Folsäure.
Was bedeuten Hb-Wert, Hämoglobin und Hämatokrit im Blutbild?
Hb-Wert
Der Hb-Wert beschreibt die Konzentration von Hämoglobin im Blut. Hämoglobin ist der rote Blutfarbstoff und transportiert Sauerstoff von der Lunge in den Körper.
Hämoglobin
Hämoglobin sitzt in den roten Blutkörperchen. Ist zu wenig Hämoglobin vorhanden, kann der Körper schlechter mit Sauerstoff versorgt werden.
Hämatokrit
Der Hämatokrit gibt an, welcher Anteil des Blutes aus roten Blutkörperchen besteht. Er verändert sich häufig parallel zu Hb-Wert und Erythrozyten.
Hb-Wert zu niedrig oder Hämatokrit zu niedrig: was bedeutet das?
Wenn der Hb-Wert zu niedrig ist, befindet sich zu wenig roter Blutfarbstoff im Blut. Wenn der Hämatokrit zu niedrig ist, ist der Anteil der roten Blutkörperchen am Blutvolumen vermindert. Beides kann auf eine Blutarmut, medizinisch Anämie, hinweisen.
Häufige Ursachen sind Eisenmangel, Blutverlust, ein Vitamin-B12-Mangel, Folsäuremangel oder chronische Erkrankungen.
Hämatokrit zu hoch oder Hb-Wert erhöht: kurz eingeordnet
Nicht nur niedrige Werte können auffallen. Auch ein erhöhter Hämatokrit oder ein erhöhter Hb-Wert sollte im Zusammenhang betrachtet werden. Häufige, eher einfache Gründe sind Flüssigkeitsmangel oder Rauchen. Es können aber auch chronischer Sauerstoffmangel, Lungenerkrankungen oder seltenere Bluterkrankungen eine Rolle spielen.
Hämatokrit zu niedrig
- passt häufig zu Blutarmut
- typisch bei Eisenmangel oder Blutverlust
- auch bei Vitamin-B12- oder Folsäuremangel möglich
- Einordnung mit MCV, MCH, MCHC sinnvoll
Hämatokrit zu hoch
- möglich bei Flüssigkeitsmangel
- möglich bei Rauchen oder Sauerstoffmangel
- auch bei bestimmten Blutbildungsstörungen möglich
- Verlauf und Begleitwerte sind entscheidend
Hämoglobin niedrig: häufige Ursachen im Überblick
Ein niedriger Hb-Wert oder Hämatokrit ist kein fertiges Urteil, sondern ein Hinweis. Die wichtigste Frage lautet: Warum ist der Wert niedrig? Genau hier beginnt die sinnvolle Diagnostik.
| Ursache | Typischer Zusammenhang | Was zusätzlich geprüft wird |
|---|---|---|
| Eisenmangel | Sehr häufige Ursache für niedrigen Hb-Wert, Müdigkeit und Leistungsknick | Ferritin, Transferrinsättigung, MCV, MCH |
| Blutverlust | Zum Beispiel starke Menstruation, Magen-Darm-Blutung, OP oder Verletzung | Verlauf, Eisenstatus, Stuhltest, weitere Diagnostik nach Situation |
| Vitamin-B12-Mangel | Kann Blutarmut und neurologische Beschwerden verursachen | Vitamin B12, Holo-TC, MCV, neurologische Symptome |
| Folsäuremangel / Vitamin B9 | Kann ebenfalls zu Blutarmut beitragen | Folsäure, MCV, Ernährung, Medikamente |
| Chronische Entzündung | Entzündungen können die Eisenverwertung und Blutbildung verändern | CRP, Ferritin, Nierenwerte, Grunderkrankungen |
| Nierenerkrankungen | Die Niere ist an der Steuerung der Blutbildung beteiligt | Kreatinin, eGFR, Urinbefund, Verlauf |
Welche Symptome passen zu niedrigem Hb-Wert oder Hämatokrit?
Alltag
- schnelle Erschöpfung
- Leistungsknick
- Konzentrationsprobleme
- ungewohnte Müdigkeit
Kreislauf und Atmung
- Kurzatmigkeit
- Schwindel
- Herzklopfen
- Belastungsintoleranz
Äußere Hinweise
- Blässe
- kalte Hände
- brüchige Nägel bei Eisenmangel
- Haarausfall bei Mangelzuständen
Welche Zusatzwerte sind bei niedrigem Hb-Wert wichtig?
Hb und Hämatokrit sind Startpunkte. Um die Ursache zu erkennen, braucht es meist weitere Werte. Besonders wichtig ist die Kombination aus Blutbild, Eisenstatus, Vitaminwerten und Entzündungswerten.
Blutbild-Werte
- Erythrozyten
- MCV, MCH und MCHC
- Retikulozyten bei spezieller Fragestellung
- Leukozyten und Thrombozyten im Gesamtbild
Mangel- und Ursachenwerte
- Ferritin und Eisenstatus bei Eisenmangel
- Vitamin B12 / Holo-TC
- Vitamin B9 / Folsäure
- CRP, Nierenwerte und weitere Werte je nach Situation
Hb-Wert erhöhen: welche Behandlung infrage kommt
Einen niedrigen Hb-Wert behandelt man nicht nach Schema F. Entscheidend ist die Ursache. Bei Eisenmangel braucht es eine andere Strategie als bei Vitamin-B12-Mangel, Blutverlust, chronischer Entzündung oder einer Nierenerkrankung.
Eisenmangel behandeln
Wenn der Eisenstatus niedrig ist, können Eisenpräparate, Ernährungsanpassung oder bei stärkerem Mangel eine Eiseninfusion sinnvoll sein.
Mehr dazu: Eisenmangel Symptome und Behandlung
Vitamin B12 prüfen
Ein Vitamin-B12-Mangel kann Blutbildveränderungen und neurologische Beschwerden verursachen. Deshalb ist B12 bei auffälligem Hb-Wert oft ein wichtiger Zusatzwert.
Blutverlust ausschließen
Bei unklar niedrigem Hb-Wert sollte immer geprüft werden, ob Blutverlust eine Rolle spielt – zum Beispiel über starke Menstruation, Magen-Darm-Trakt, Operationen oder andere Ursachen.
Wie wir auffällige Hb- und Hämatokritwerte in der Praxis einordnen
In der Hausarztpraxis am Romanplatz betrachten wir auffällige Blutwerte immer im Zusammenhang: Beschwerden, Verlauf, Ernährung, Medikamente, Vorerkrankungen, Blutverlust und ergänzende Laborwerte.
Typische nächste Schritte
- Einordnung des Blutbilds mit Hb, Hämatokrit und Erythrozyten
- Prüfung von MCV, MCH und MCHC
- Eisenstatus mit Ferritin bei Verdacht auf Eisenmangel
- Vitamin-Diagnostik mit Vitamin B12 und Folsäure
- weitere Abklärung bei Blutverlust, Entzündung oder chronischer Erkrankung

Weitere passende Blutbild- und Mangel-Themen
Diese Seiten helfen, Hb-Wert, Hämatokrit, Eisenmangel und weitere Blutbildveränderungen im Zusammenhang zu verstehen.
Medizinische Grundlagen und weiterführende Informationen
Für Leserinnen und Leser, die tiefer einsteigen möchten, sind diese unabhängigen Quellen hilfreich.
FAQ: Hb-Wert, Hämoglobin und Hämatokrit
Was bedeutet der Hb-Wert?
Der Hb-Wert beschreibt die Menge an Hämoglobin im Blut. Hämoglobin ist der rote Blutfarbstoff und transportiert Sauerstoff von der Lunge in Organe und Gewebe.
Was bedeutet Hämatokrit?
Der Hämatokrit beschreibt den Anteil der roten Blutkörperchen am gesamten Blutvolumen. Er wird zusammen mit Hb-Wert und Erythrozyten beurteilt.
Was bedeutet ein zu niedriger Hb-Wert?
Ein zu niedriger Hb-Wert kann auf eine Blutarmut hinweisen. Häufige Ursachen sind Eisenmangel, Blutverlust, Vitamin-B12-Mangel, Folsäuremangel oder chronische Erkrankungen.
Was bedeutet Hämatokrit zu niedrig?
Ein niedriger Hämatokrit bedeutet, dass der Anteil der roten Blutkörperchen am Blutvolumen vermindert ist. Das kann zusammen mit niedrigem Hb-Wert und niedrigen Erythrozyten zu einer Blutarmut passen.
Welche Symptome passen zu niedrigem Hb oder Hämatokrit?
Typische Beschwerden sind Müdigkeit, Blässe, Kurzatmigkeit, Schwindel, Herzklopfen, Konzentrationsprobleme und geringere Belastbarkeit.
Welche Werte sollte man bei niedrigem Hb zusätzlich prüfen?
Häufig sinnvoll sind Erythrozyten, MCV, MCH, MCHC, Ferritin beziehungsweise Eisenstatus, Vitamin B12, Folsäure, CRP und je nach Situation Nierenwerte oder weitere Diagnostik.
Kann Eisenmangel den Hb-Wert senken?
Ja. Eisenmangel ist eine der häufigsten Ursachen für einen niedrigen Hb-Wert. Eisen wird für die Bildung von Hämoglobin benötigt. Bei ausgeprägtem Mangel kann neben Tabletten auch eine Eiseninfusion infrage kommen.
Kann Vitamin-B12-Mangel den Hb-Wert verändern?
Ja. Ein Vitamin-B12-Mangel kann zu Blutbildveränderungen führen und zusätzlich neurologische Beschwerden verursachen.
Blutwerte auffällig? Wir ordnen Hb, Hämatokrit und Eisenstatus medizinisch ein.
In der Hausarztpraxis am Romanplatz prüfen wir nicht nur Einzelwerte, sondern den Zusammenhang: Beschwerden, Blutbild, Eisenstatus, Vitamin B12, Folsäure und mögliche Ursachen.
